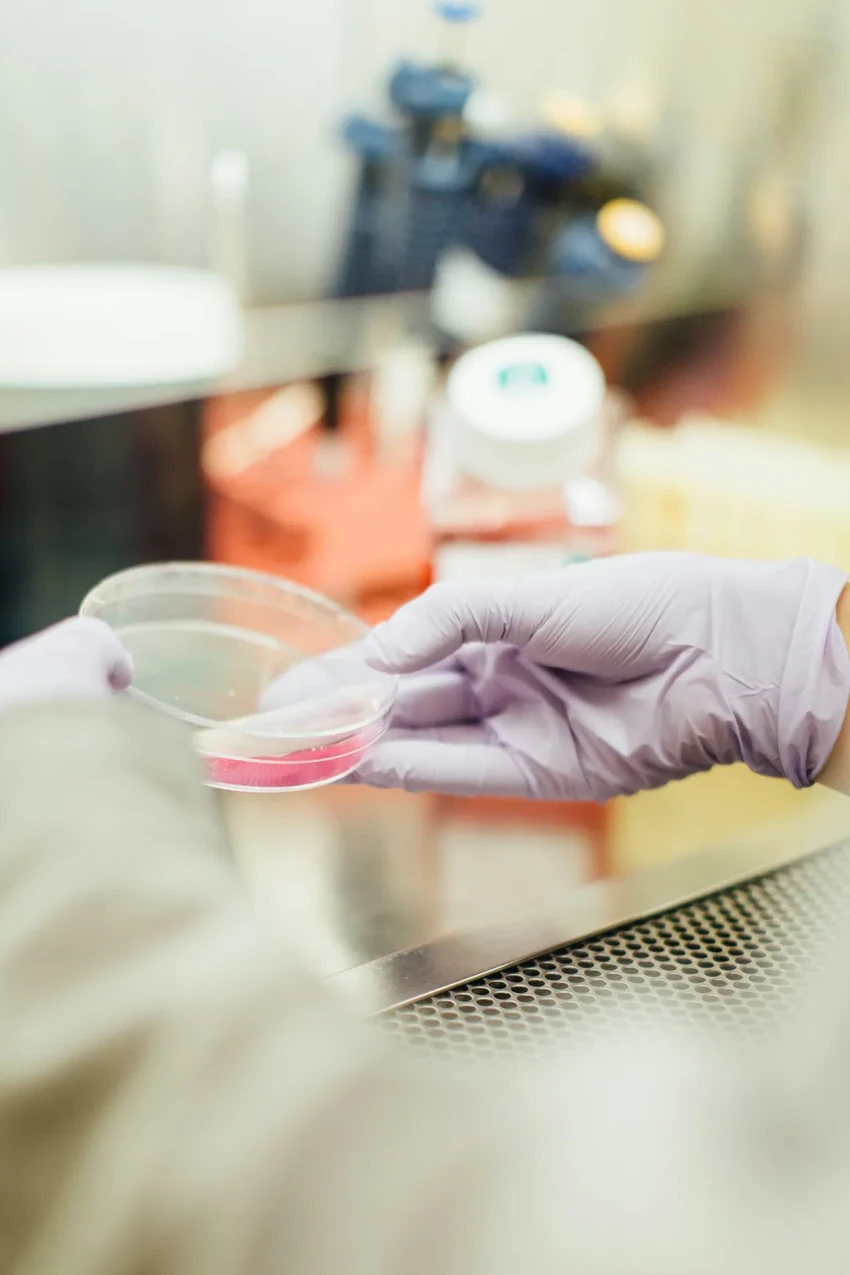
Артемизинин против СПКЯ: как древнее лекарство помогает при поликистозе

Артемизинин против СПКЯ: как древнее лекарство помогает при поликистозе
Новое исследование предлагает взглянуть на старый препарат под совершенно новым углом. Артемизинин, веками использовавшийся в китайской медицине против малярии, продемонстрировал удивительный эффект: он нормализует гормональный фон при СПКЯ.
В течение 12 недель приема у женщин стали более регулярными менструальные циклы. Результаты скромного, но тщательного исследования китайской команды были восприняты научным сообществом как потенциальный прорыв. Наконец-то может появиться принципиально новая опция в лечении.

«Получить совершенно новое лекарство для лечения такого сложного состояния — большая редкость. Это очень важно, — говорит доктор Чанна Джаясена из Имперского колледжа Лондона, не участвовавшая в работе. — Потенциал здесь огромен. И это особенно ценно, ведь проблемам женского здоровья исторически уделялось меньше внимания, чем, скажем, болезням сердца».
Чем лечат СПКЯ сейчас и почему этого мало
Сегодня стандартный подход часто сводится к назначению оральных контрацептивов. Они подавляют выработку тестостерона и помогают регулировать цикл. Для борьбы с бесплодием используют специальные препараты или даже хирургию. Но у этих методов есть ограничения: они подходят не всем, не всегда эффективны и не решают проблему комплексно. Женщинам часто приходится мириться с симптомами или мириться с побочными эффектами лечения. Не слишком ли это устаревший подход для XXI века?
А теперь — наука в действии. Исследование, опубликованное в журнале Science, раскрыло механизм. Артемизинин блокирует ключевой фермент CYP11A1, который играет роль «дирижера» в производстве тестостерона в яичниках. Убедительные эксперименты на грызунах с моделью СПКЯ показали: препарат снижает уровень мужского гормона и восстанавливает фертильность.
Но главное — клинические данные. В пилотном исследовании участвовали 19 женщин с СПКЯ. После трех месяцев приема артемизинина у них значительно снизился уровень гормонов, УЗИ показало уменьшение количества незрелых фолликулов, а у 12 участниц (63%) восстановился регулярный цикл. И что особенно важно — серьезных побочных эффектов зафиксировано не было.
«Наши результаты показывают, что артемизинины — многообещающие кандидаты для лечения СПКЯ, — резюмирует руководитель исследования профессор Ци-цюнь Тан из Университета Фудань. — Они эффективно подавляют синтез андрогенов в яичниках, уменьшают скопление фолликулов и нормализуют менструальный цикл».










